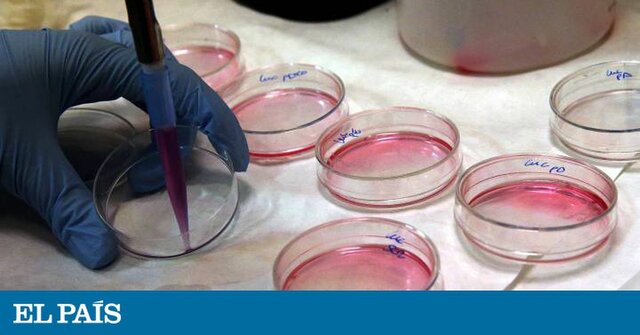
La primera terapia génica aprobada en un paciente humano

-
 Robert Briggs y Thomas King clonan al primer invertebrado trasplantando núcleos de embriones de ranas leopardo en huevos enucleados.
Robert Briggs y Thomas King clonan al primer invertebrado trasplantando núcleos de embriones de ranas leopardo en huevos enucleados. -
 Severo Ochoa descubre una enzima de una célula bacteriana de Escherichia coli, cuya función catalítica es la síntesis de ARN (ácido ribonucleico) la molécula necesaria para la síntesis de proteínas.
Severo Ochoa descubre una enzima de una célula bacteriana de Escherichia coli, cuya función catalítica es la síntesis de ARN (ácido ribonucleico) la molécula necesaria para la síntesis de proteínas. -
 Max Perutz presenta un modelo para representar la estructura de la Hemoglobina, esta es la proteína que transporta oxigeno en la sangre
Max Perutz presenta un modelo para representar la estructura de la Hemoglobina, esta es la proteína que transporta oxigeno en la sangre -
 Robert Woodward, un químico estadounidense logra sintetizar la molécula clorofila.
Robert Woodward, un químico estadounidense logra sintetizar la molécula clorofila. -
Juan Oró descubre que las soluciones concentradas de cianuro de amonio en el agua pueden el nucleótido adenina. Todo esto hizo paso a teorías sobre el origen de la vida.
-
 Lynn Margulis hace la teoría endosimbiótica de que la célula eucariota es una unión simbiótica de células procariotas primitivas. Esta fue nombrada como uno de de los grandes logros de la biología evolutiva del siglo XX.
Lynn Margulis hace la teoría endosimbiótica de que la célula eucariota es una unión simbiótica de células procariotas primitivas. Esta fue nombrada como uno de de los grandes logros de la biología evolutiva del siglo XX. -
 Roberth H Whittaker propone clasificar por grupos a los seres vivos, estos son 5, son los reinos de: ANIMAL, VEGETAL, MONERA, HONGO Y PROTISTA. Se hacía esta división por diferentes características de estos seres vivos, estas son: morfológicas y genéticas.
Roberth H Whittaker propone clasificar por grupos a los seres vivos, estos son 5, son los reinos de: ANIMAL, VEGETAL, MONERA, HONGO Y PROTISTA. Se hacía esta división por diferentes características de estos seres vivos, estas son: morfológicas y genéticas. -
 Dorothy Crowfoot Hodgkin descifra la estructura tridimensional de la insulina. Logra esto con la ayuda de la cristalografía de rayos X, con esta no solo descifro la estructura de la insulina, también de muchas moléculas biológicas.
Dorothy Crowfoot Hodgkin descifra la estructura tridimensional de la insulina. Logra esto con la ayuda de la cristalografía de rayos X, con esta no solo descifro la estructura de la insulina, también de muchas moléculas biológicas. -
 En 1972, Stephen Jay Gould junto con Niles Eldredge hacen la teoría de que la mayoría de los procesos evolutivos están compuestos por largos períodos de estabilidad, interrumpidos por episodios cortos y poco frecuentes de bifurcación evolutiva.
En 1972, Stephen Jay Gould junto con Niles Eldredge hacen la teoría de que la mayoría de los procesos evolutivos están compuestos por largos períodos de estabilidad, interrumpidos por episodios cortos y poco frecuentes de bifurcación evolutiva. -
Georges Kohler y Cesar Milstein producen un tipo de anticuerpo "monoclonal" ("son proteínas producidas en laboratorio que imitan la capacidad del sistema inmunológico para combatir antígenos dañinos como los virus") fusionaron células leucémicas de ratón con linfocitos, con lo cual desarrollan, clones y estos clones son los anticuerpos monoclonales.
-
 Walter Gilbert y Allan Maxam presentan una técnica para la secuenciación de ADN, esta utiliza la clonación el gel de electroforesis, la destrucción química de las bases.
Walter Gilbert y Allan Maxam presentan una técnica para la secuenciación de ADN, esta utiliza la clonación el gel de electroforesis, la destrucción química de las bases. -
 Carl Woese descubre que las bacterias no son los únicos seres unicelulares procariotas en la Tierra. Muchos o la mayoría de estos organismos son extremófilos.
Carl Woese descubre que las bacterias no son los únicos seres unicelulares procariotas en la Tierra. Muchos o la mayoría de estos organismos son extremófilos. -
 Stanley B. Prusiner propone la existencia de proteínas infecciosas o priones. Su idea es ampliamente ridiculizada en la comunidad científica, pero gana un Premio Nobel en 1997.
Stanley B. Prusiner propone la existencia de proteínas infecciosas o priones. Su idea es ampliamente ridiculizada en la comunidad científica, pero gana un Premio Nobel en 1997. -
 Alec Jeffreys invento la técnica de huellas genéticas de ADN, este invento fue de gran ayuda para la ciencia forense.
Alec Jeffreys invento la técnica de huellas genéticas de ADN, este invento fue de gran ayuda para la ciencia forense. -
 En 1986 Rita Levi-Montalcini y Stanley Cohen reciben el premio nobel por el descubrimiento de los factores de crecimiento nervioso..
En 1986 Rita Levi-Montalcini y Stanley Cohen reciben el premio nobel por el descubrimiento de los factores de crecimiento nervioso.. -
 Alexander Klibanov hace una demostración de que las enzimas si pueden funcionar en ambientes no acuosos.
Alexander Klibanov hace una demostración de que las enzimas si pueden funcionar en ambientes no acuosos. -
French Anderson realiza la primera terapia génica aprobada en un paciente humano. Fue usada por primera vez con intención terapéutica en un paciente que padecía una inmunodeficiencia severa por un déficit de adenosina deaminasa. El error genético se corrigió.
French Anderson realiza la primera terapia génica aprobada en un paciente humano. Fue usada por primera vez con intención terapéutica en un paciente que padecía una inmunodeficiencia severa por un déficit de adenosina deaminasa. El error genético se corrigió. -
 El año 1995, fue secuenciado el genoma completo de la bacteria Haemophilus influenzae, primer ser viviente de vida autónoma cuyo patrimonio genético era totalmente develado.
El año 1995, fue secuenciado el genoma completo de la bacteria Haemophilus influenzae, primer ser viviente de vida autónoma cuyo patrimonio genético era totalmente develado. -
 En 1996 la Oveja Dolly fue clonada a partir de una célula adulta. Los cientificos que crearon a Dolly fueron: Ian Wilmut y Keith Campbell.
En 1996 la Oveja Dolly fue clonada a partir de una célula adulta. Los cientificos que crearon a Dolly fueron: Ian Wilmut y Keith Campbell. -
 Mello y Fire hacen el descubrimiento de un mecanismo que puede degradar el ARNm de un gene específico. Con esto comparten un premio nobel Fisiología o Medicina.
Mello y Fire hacen el descubrimiento de un mecanismo que puede degradar el ARNm de un gene específico. Con esto comparten un premio nobel Fisiología o Medicina.
Plan projects on a visual timeline
Map milestones, phases, deadlines, and key events in one place so the sequence is easier to see and share. Timetoast is a timeline maker for work, school, research, and stories.

